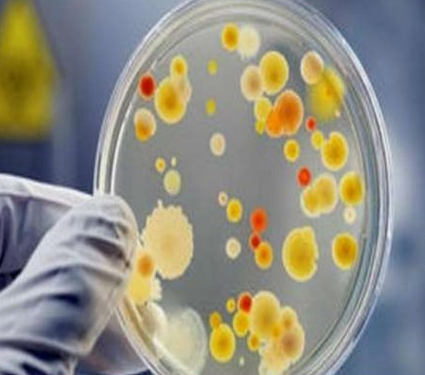

Выезд травматолога-ортопеда, рентгенолога Александра Валерьевича Дидковского.
На рабочем месте производится обучение работе на Вашем оборудовании.
Любого доктора можно быстро подготовить как рентгенлаборанта и дать необходимые знания для оценки рентгенограмм.
Изучение проблемы низкого качества рентгенограмм на Вашем оборудовании.
Мобильный рентгенаппарат + оцифровщик. Получение рентгеновского изображения на экране ноутбука. Вариант за 1,4 миллиона рублей под ключУРА
Мобильный рентгенаппарат с печатью рентгенограмм на рентгеновской пленке. Цена 700000 рублей.
Магнитно-резонансная томография (МРТ):один из самых эффективных методов диагностики заболеваний
В случае перелома шейки бедра компания МосРентген Центр госпитализирует в Склиф для эндопротезирования.
Радиационно-гигиенические паспорта и отчеты №1-ДОЗ №3-ДОЗ для предприятий из Москвы и регионов РФ - оформление документов. Как правильно оформить отчеты №1-ДОЗ №3-ДОЗ за 2024 год
Создание рентгеновского бизнеса для ветеринаров с нуля за 185000 рублей.
Получение санитарно-эпидемиологическое заключение на осуществление деятельности в области работы (ИИИ).